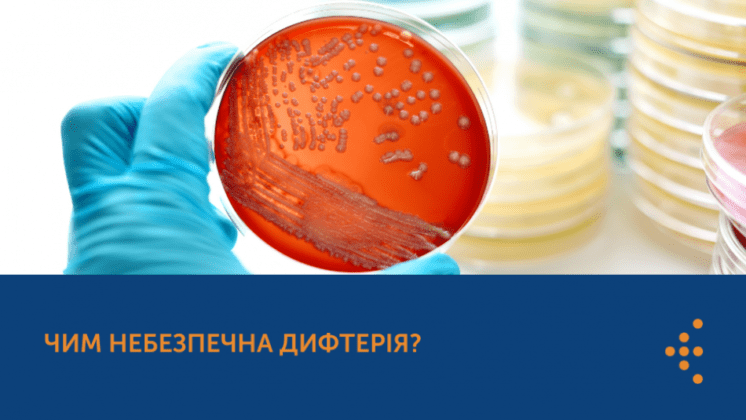
ЧИМ НЕБЕЗПЕЧНА ДИФТЕРІЯ?

Щороку мільйони пацієнтів у світі страждають від інфекцій, що виникають унаслідок надання медичної допомоги. До 70 % таких інфекцій можна запобігти, дотримуючись належних заходів профілактики. Уявіть світ, де інфекції не мають шансів! Цьогорічний Міжнародний тиждень профілактики інфекцій — нагода для всіх […]

Все, що потрібно знати про легені та рак легень
Сьогодні, 25 вересня, у Всесвітній день легень, хочемо привернути вашу увагу до захисту здоров’я цього життєво важливого органа людини. Починаючи з 2016 року саме цей день нагадує нам про важливість раннього виявлення, профілактики та ефективного лікування різних захворювань легень, зокрема […]

Вакцинація проти дифтерії, правця та кашлюку: чи існують протипоказання?
Перед вакцинацією у багатьох виникають різні питання. Наприклад, хтось може застудитися і задуматися, чи варто відкладати щеплення, інші ж люди можуть переживати через хронічні хвороби або ослаблений імунітет. Такі питання природні, адже кожен хоче мінімізувати ризики. Саме тому важливо пам’ятати, […]

Всесвітній день боротьби з вірусними гепатитами 2024: настав час діяти
Щорічно 28 липня світ відзначає Всесвітній день боротьби з вірусними гепатитами. Цей день запроваджений для підвищення обізнаності про проблему вірусних гепатитів, способи профілактики та лікування, а також зниження рівня стигматизації людей, які живуть з вірусним гепатитом. Основний акцент – на […]

З Днем медичного працівника!
Відтепер в Україні День медичного працівника щороку відзначатимуть 27 липня. Відповідний Указ підписав Президент України Володимир Зеленський. З нагоди Дня медичного працівника хочеться висловити вам свою вдячність за те, що ви присвячуєте своє життя збереженню та покращенню здоров’я людей. В […]

24 березня відзначається день боротьби з туберкульозом
В Україні, у зв’язку з цим, триває «Місячник боротьби із захворюванням на туберкульоз», який розпочався 01 березня та продовжиться до кінця місяця. За ініціативою Центру громадського здоров’я, у цьому році він проводиться під гаслом «Так! Ми можемо подолати туберкульоз». Таким […]

ЩО НЕОБХІДНО ЗНАТИ ПРО РАК?
Сьогодні, 4 лютого Всесвітній день боротьби проти раку. Це важливий час, щоб дізнатися більше про те, чому виникає хвороба, як її профілактувати та зменшити ризик появи онкологічних захворювань в цілому. Функціонування нашого організму — це складна, унікальна й інколи зовсім […]
ЧИМ НЕБЕЗПЕЧНА ДИФТЕРІЯ?
Дифтерія – це інфекційна хвороба, збудником якої є бактерія Corynebacterium diphtheriae. Вона небезпечна тим, що виробляє токсин, який перешкоджає утворенню білка в організмі, а на місці запалення утворюється плівка, яка може призвести до утруднення дихання й асфіксії (патологічний стан, при […]

ЗАХИСТ ВІД КОРУ: КОМУ Й КОЛИ ПОТРІБНО ВАКЦИНУВАТИСЯ
Кір небезпечний для всіх невакцинованих дітей та дорослих. Тому в ЮНІСЕФ розповіли, кому та коли потрібно вакцинуватися проти цього захворювання. Коли дитині потрібен негайний захист від кору? Якщо дитині виповнилося 12 місяців, не зволікайте зі щепленням КПК. Та якщо дитина старша […]

Чим небезпечний безконтрольний прийом калію йодиду?
При аваріях на ядерних об’єктах може виділятися радіоактивний йод (I-131). При надходженні в організм він вибірково накопичується в щитоподібній залозі і спричиняє її опромінення й ураження. Це підвищує ризик раку щитоподібної залози у немовлят, дітей та молодих людей через багато […]

